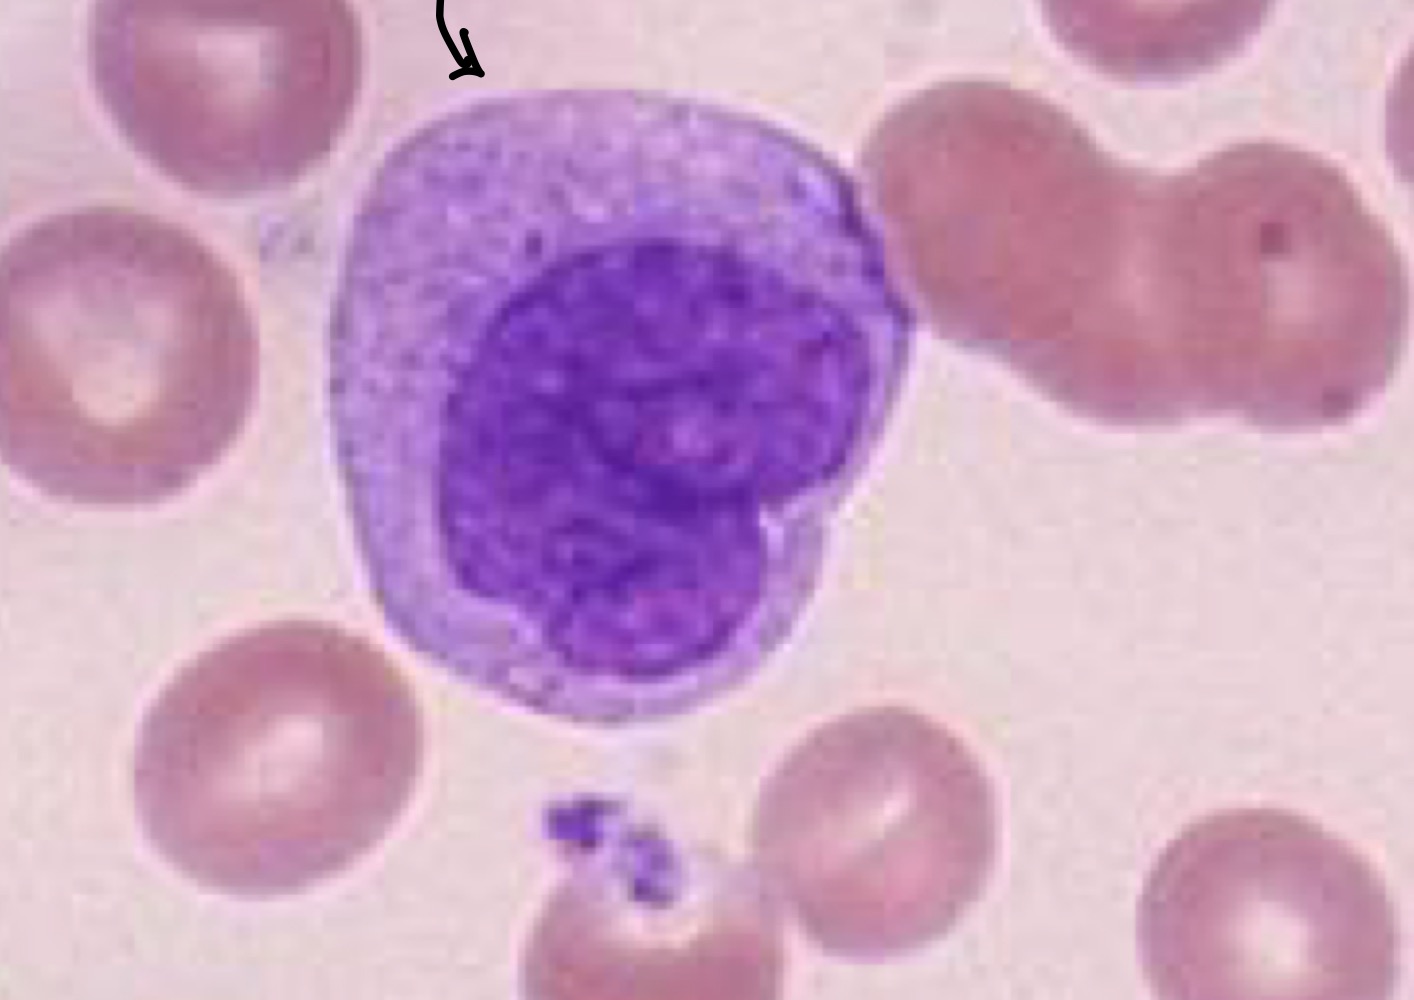
Identify this cell.
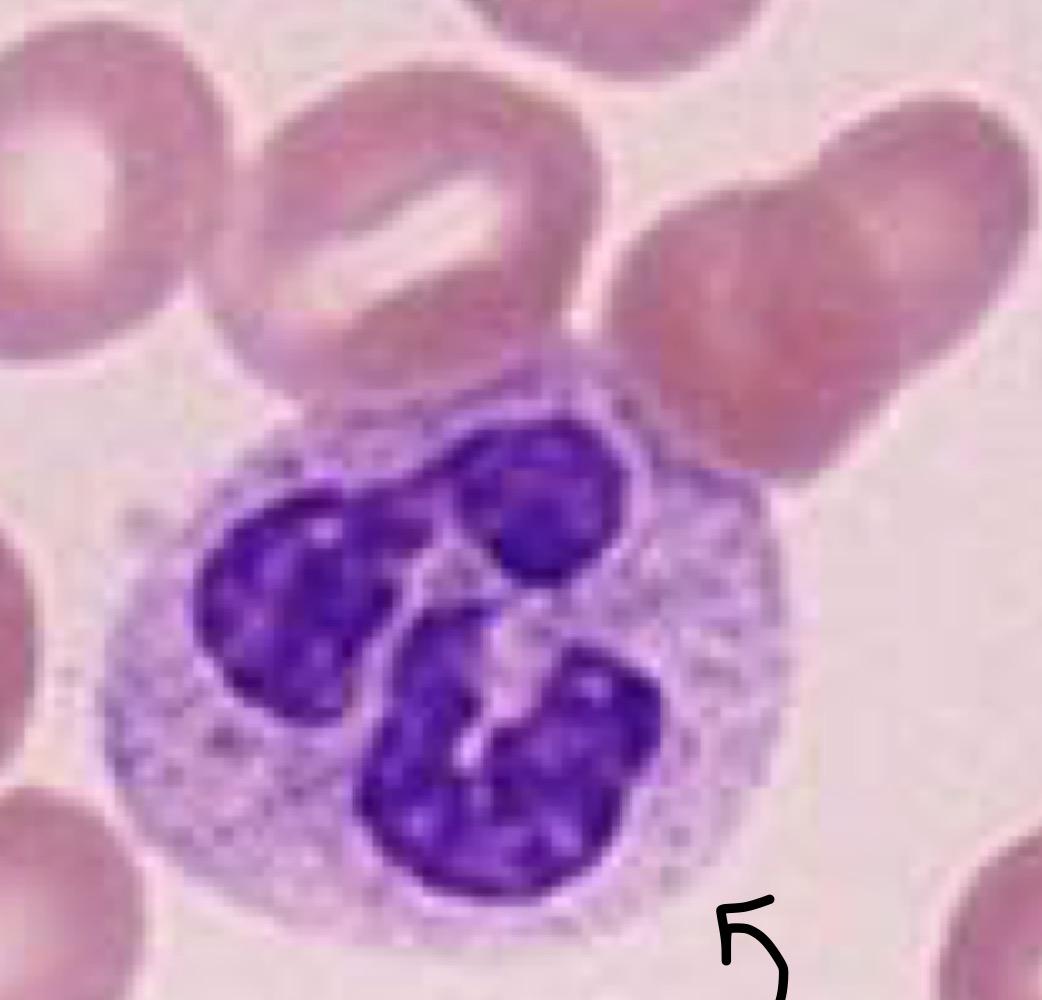
Identify this cell.
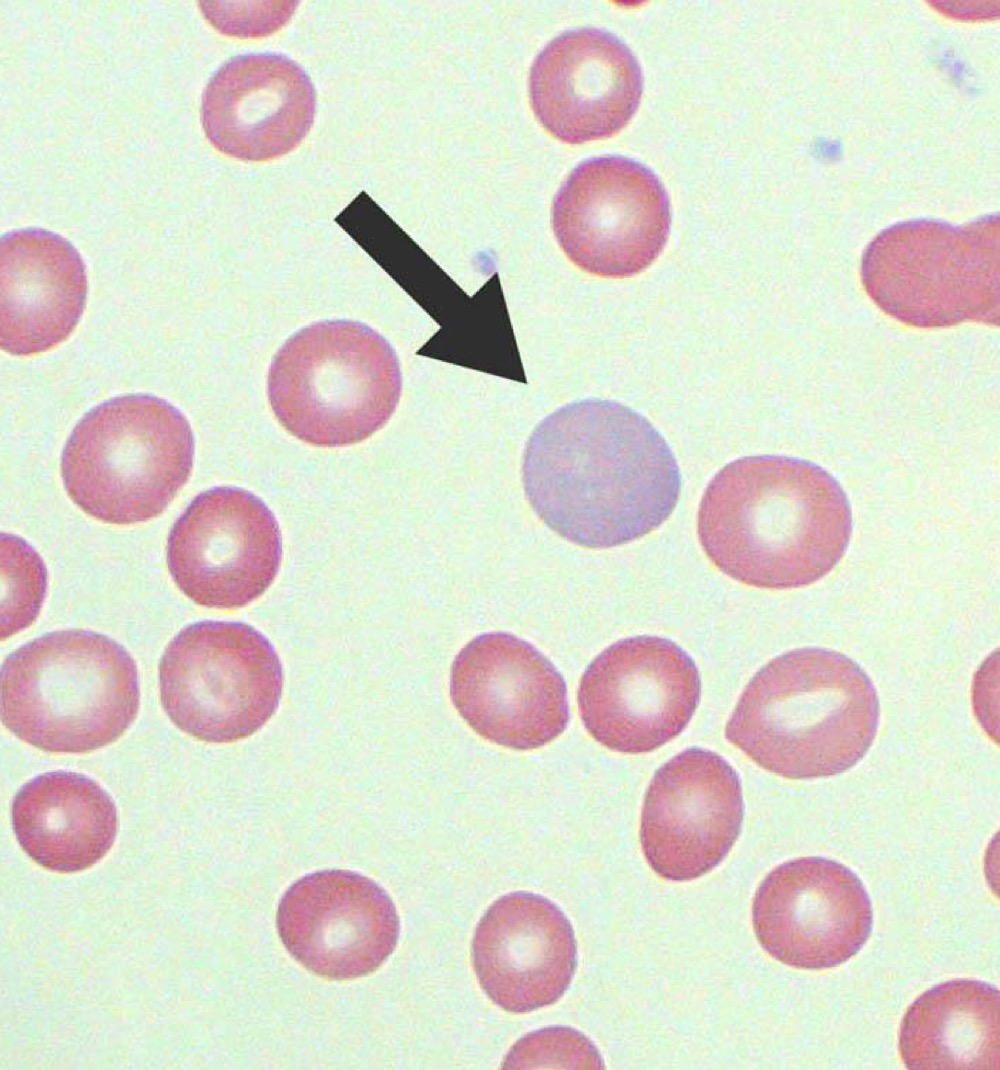
Name this RBC Abnormality.
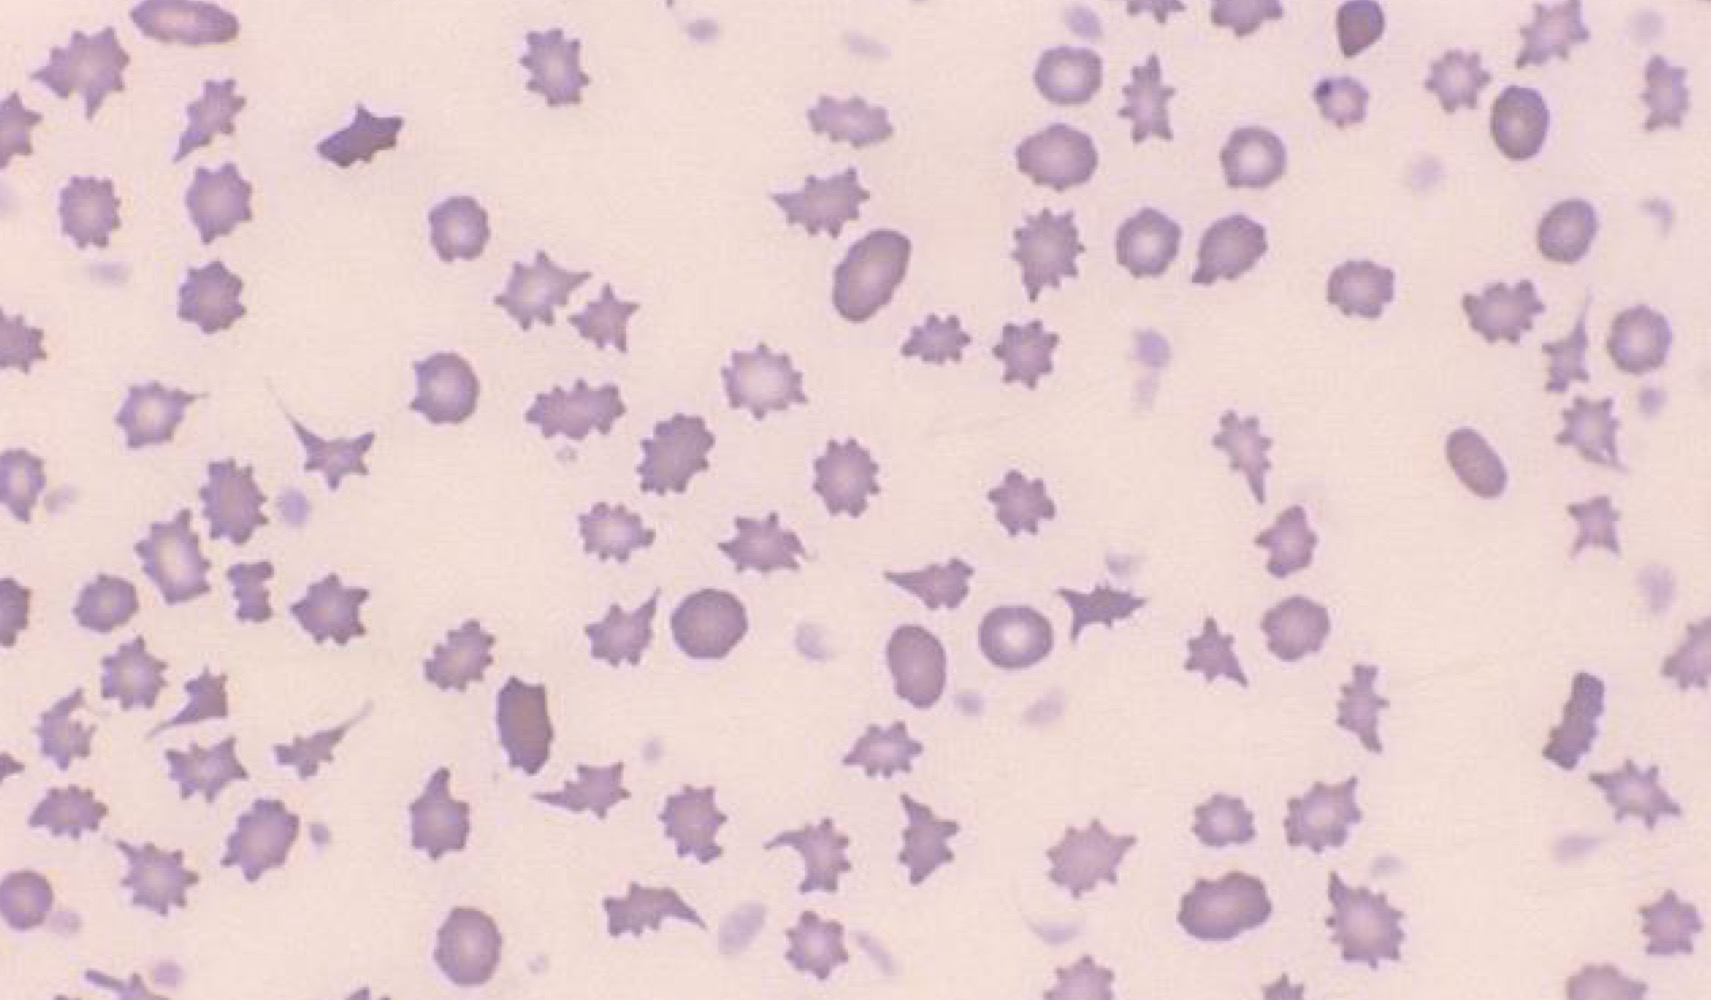
Name this RBC Abnormality.
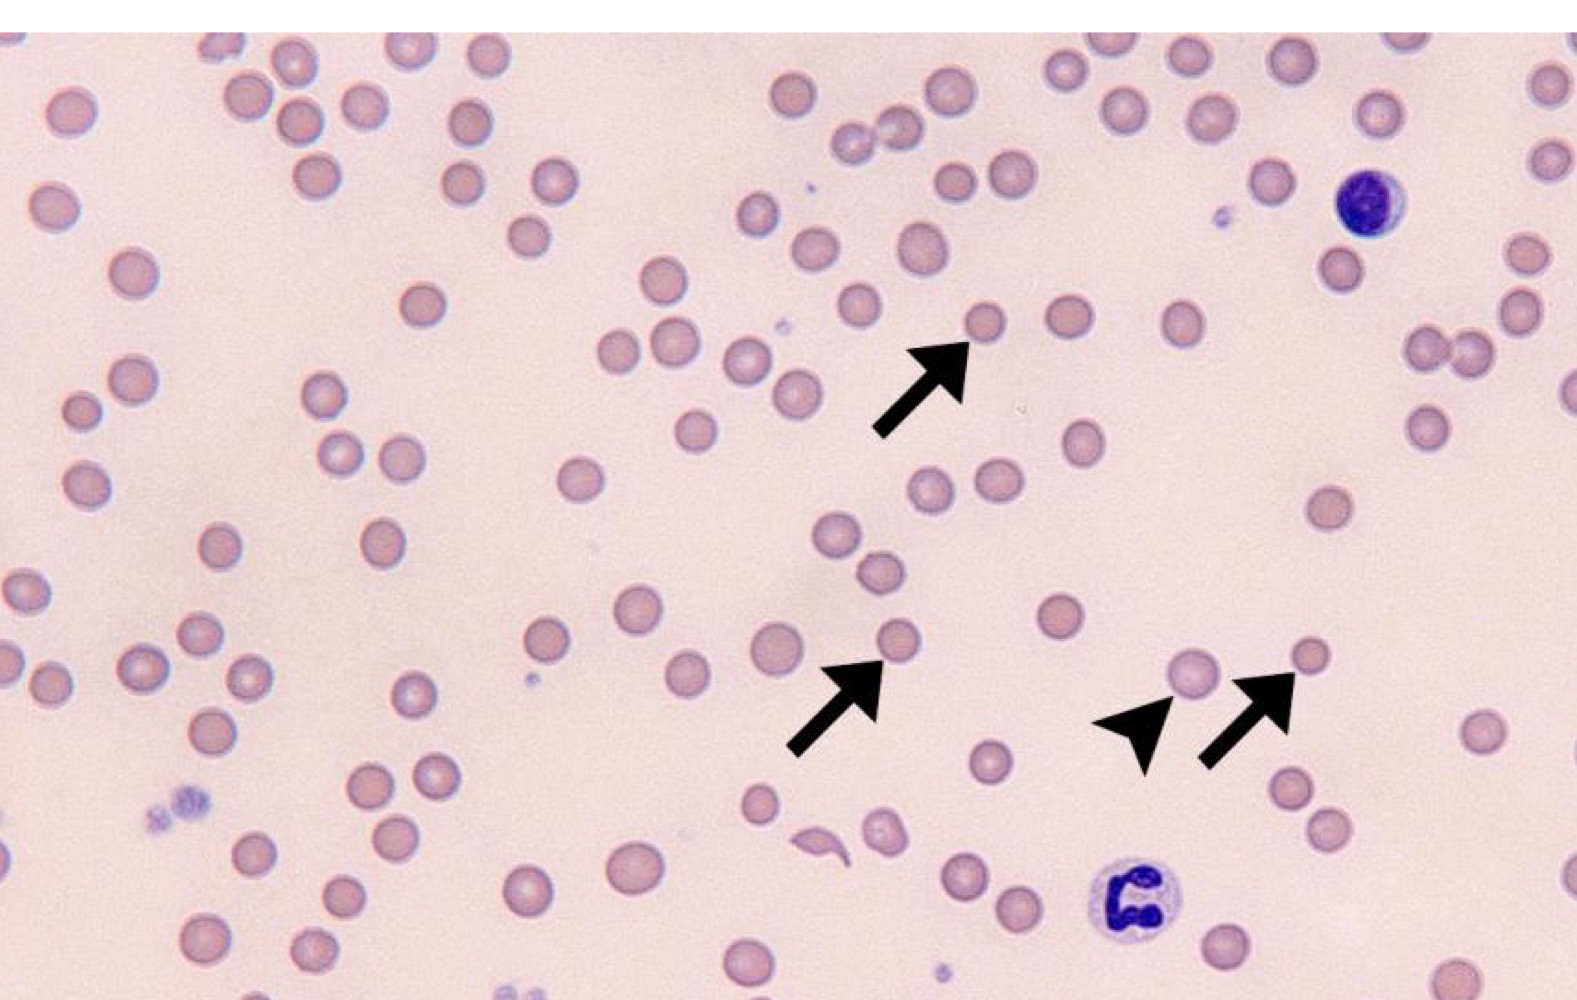
Name this RBC Abnormality.
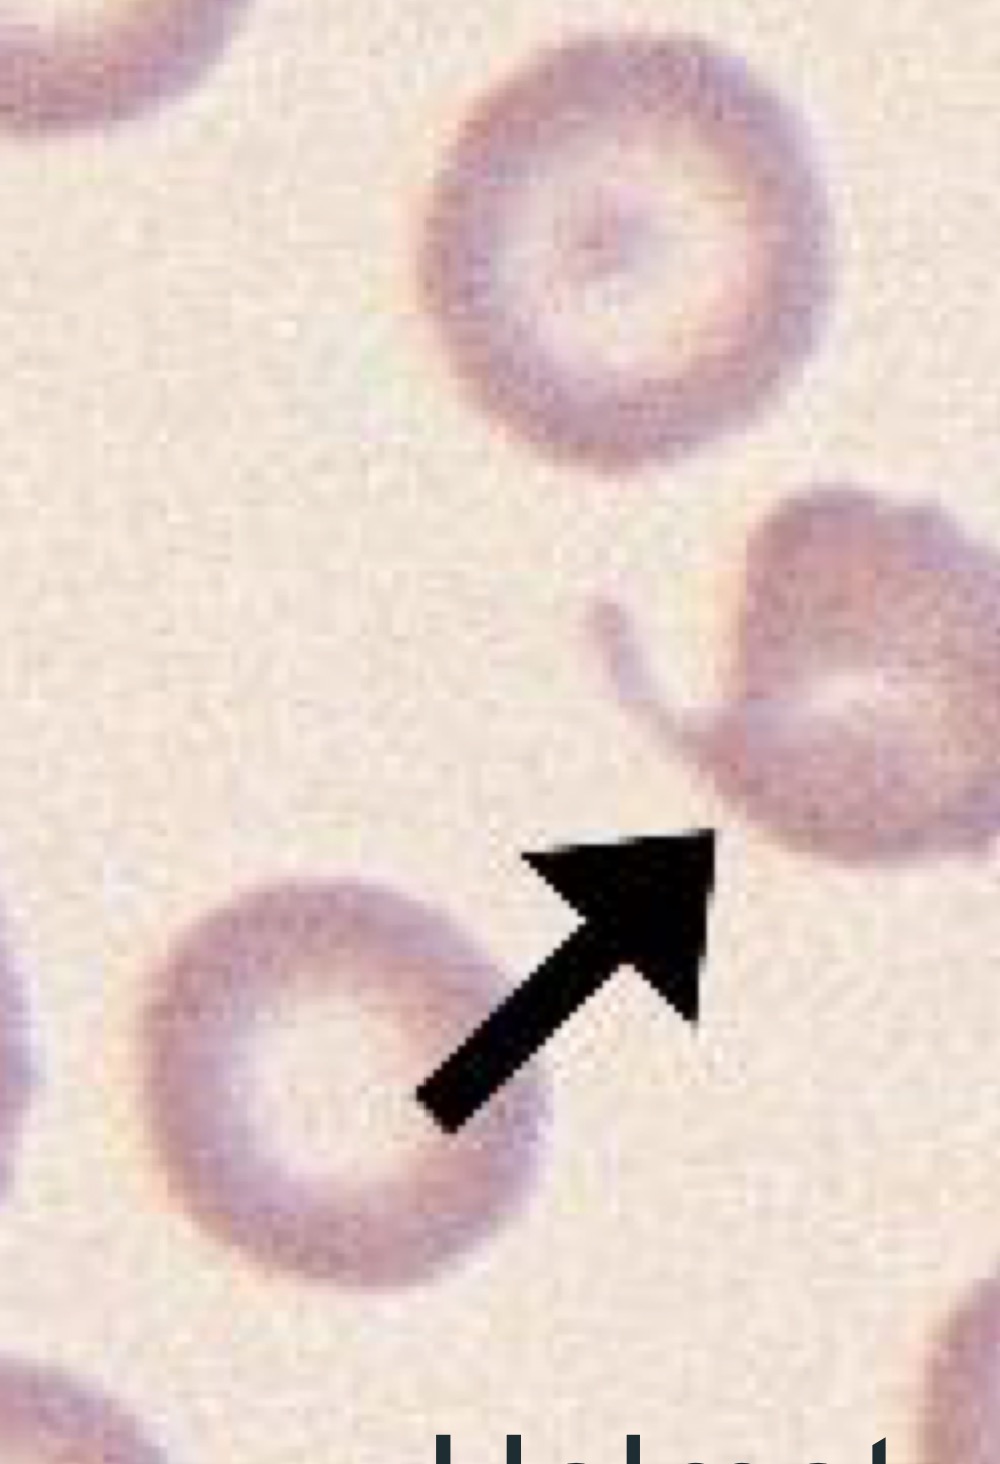
Name this RBC Abnormality.
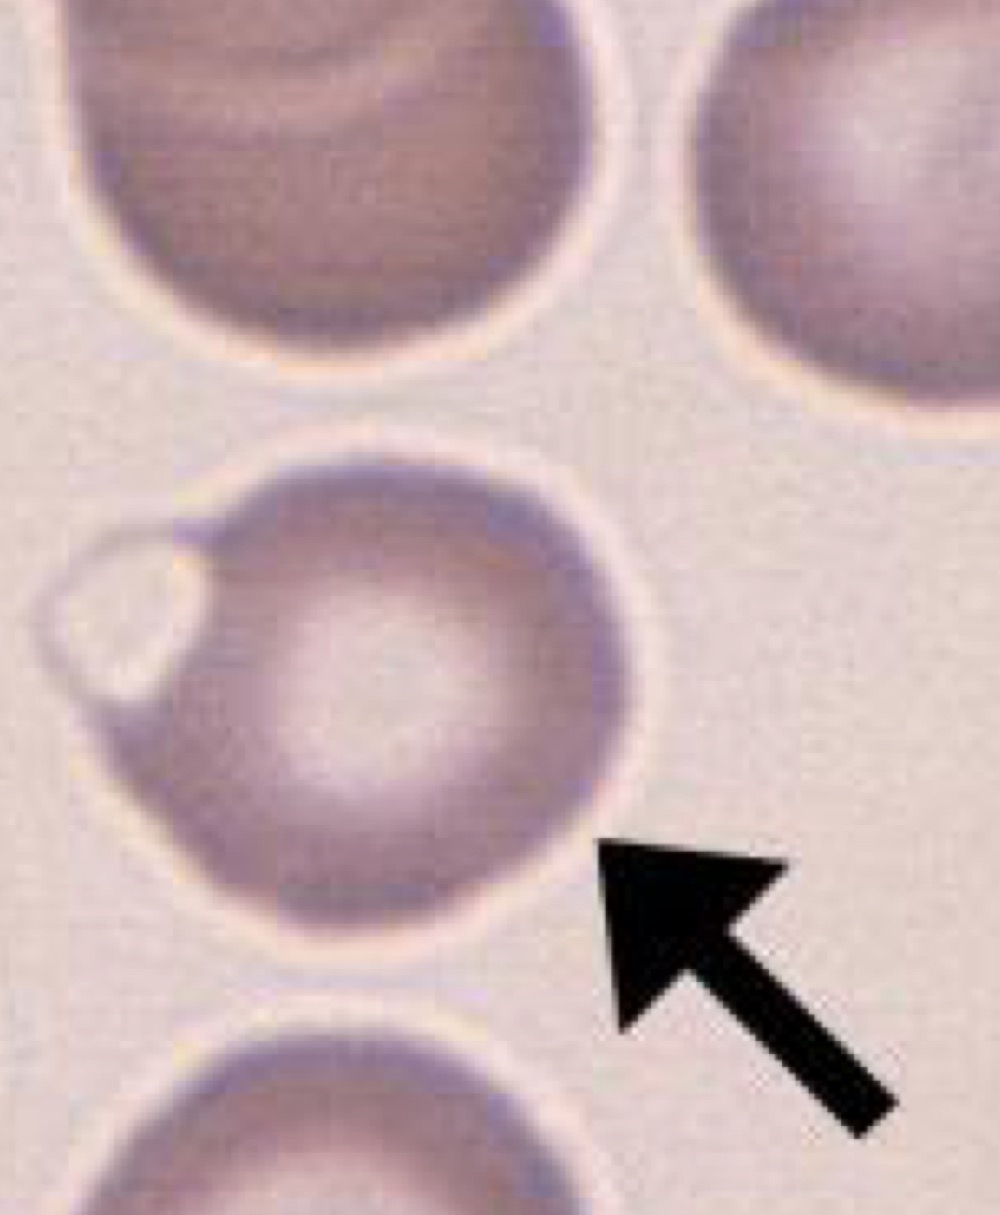
Name this RBC Abnormality.
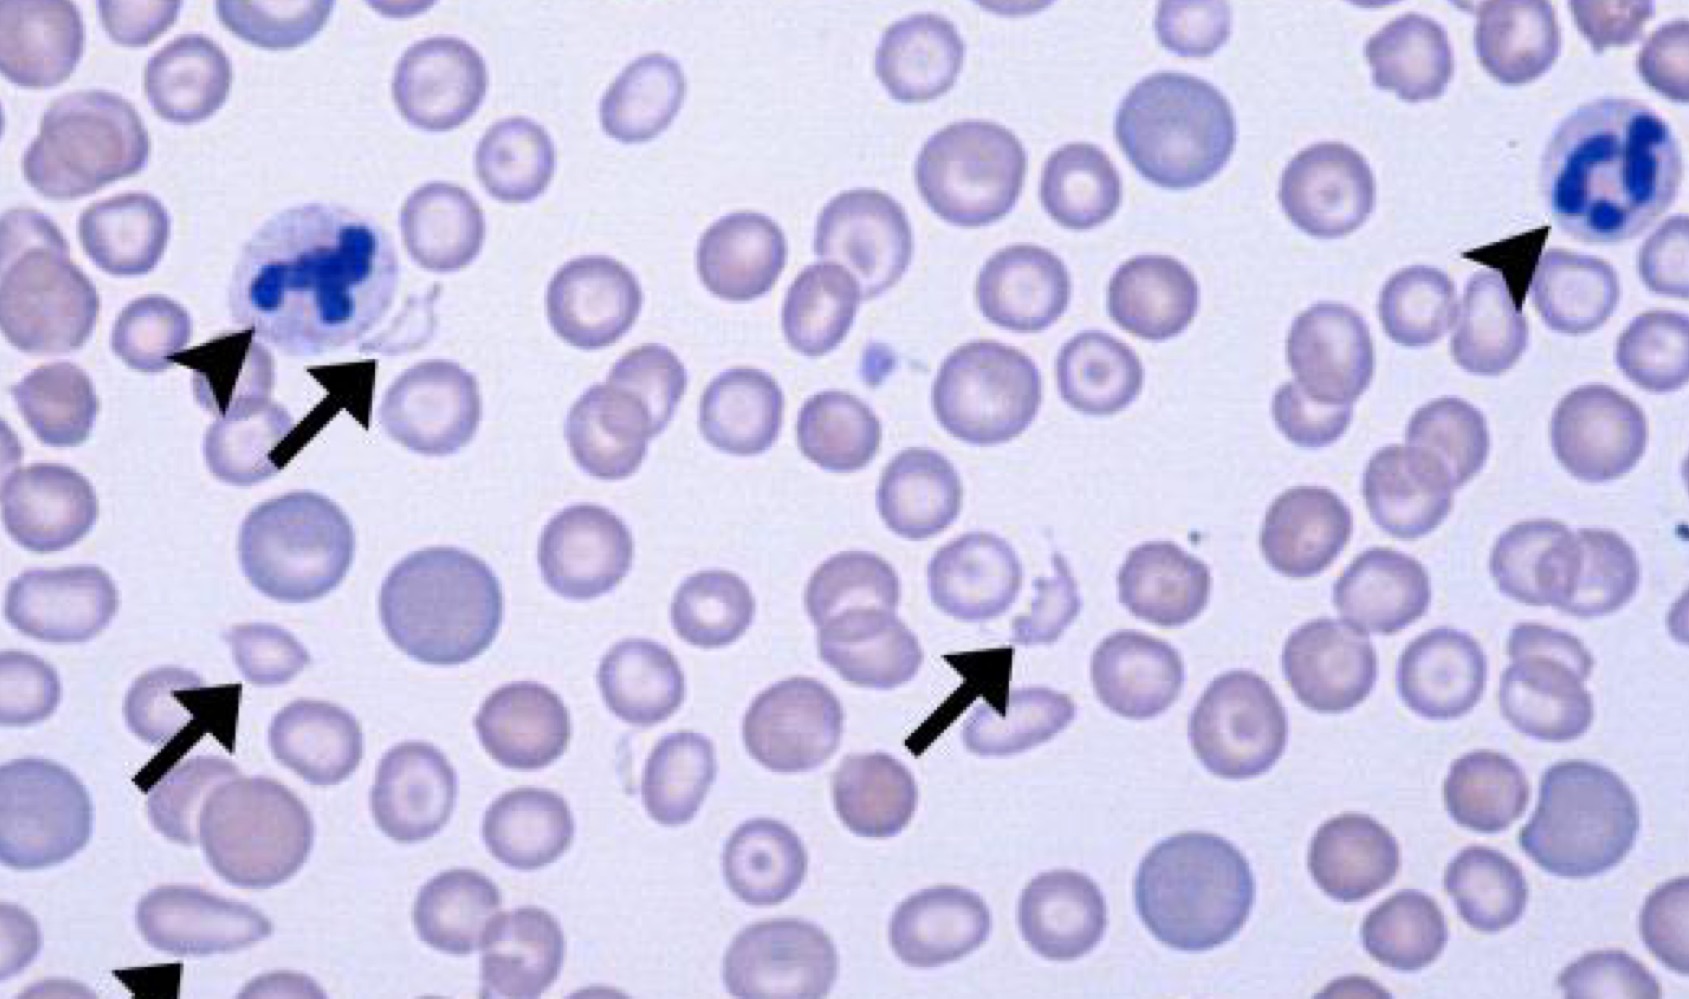
Name this RBC Abnormality.
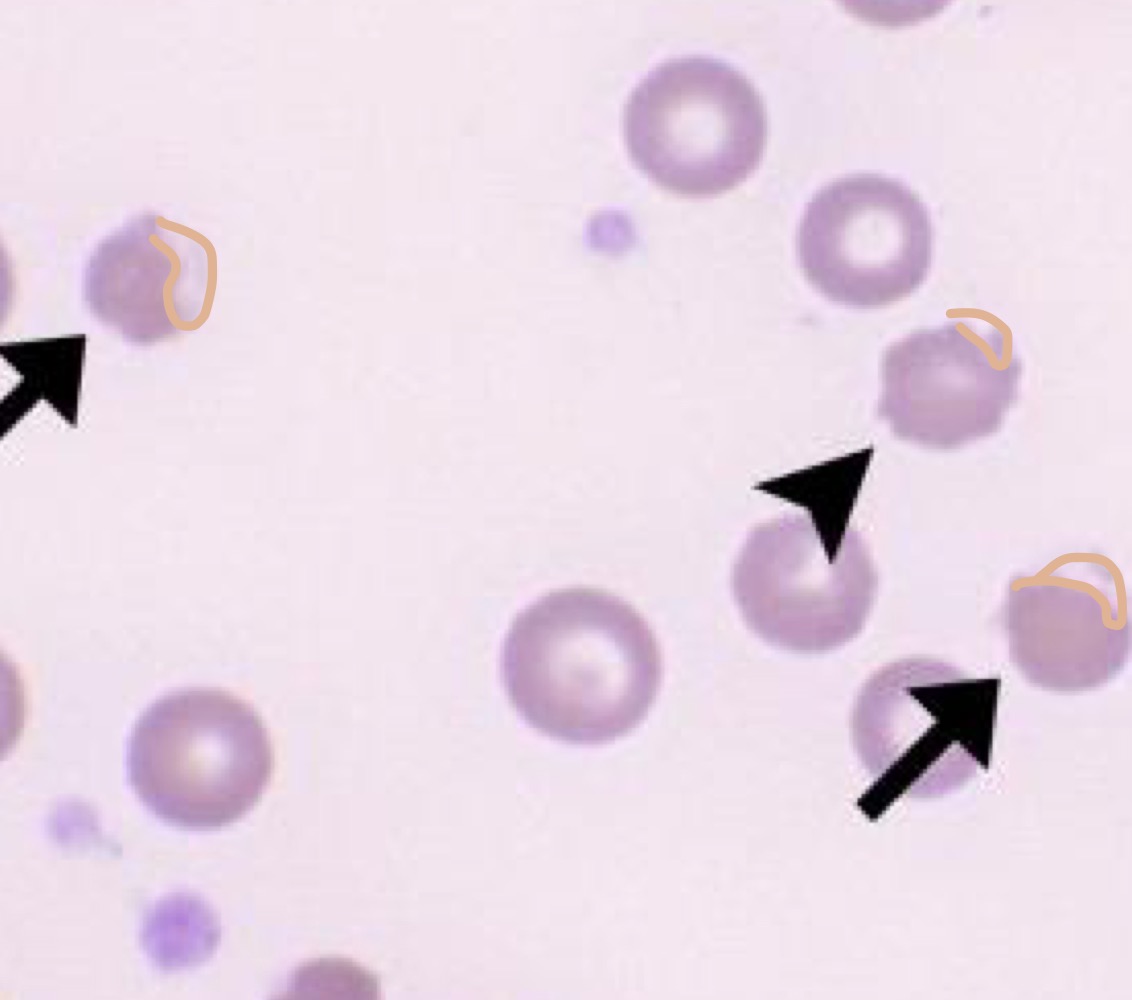
Name this RBC Abnormality.
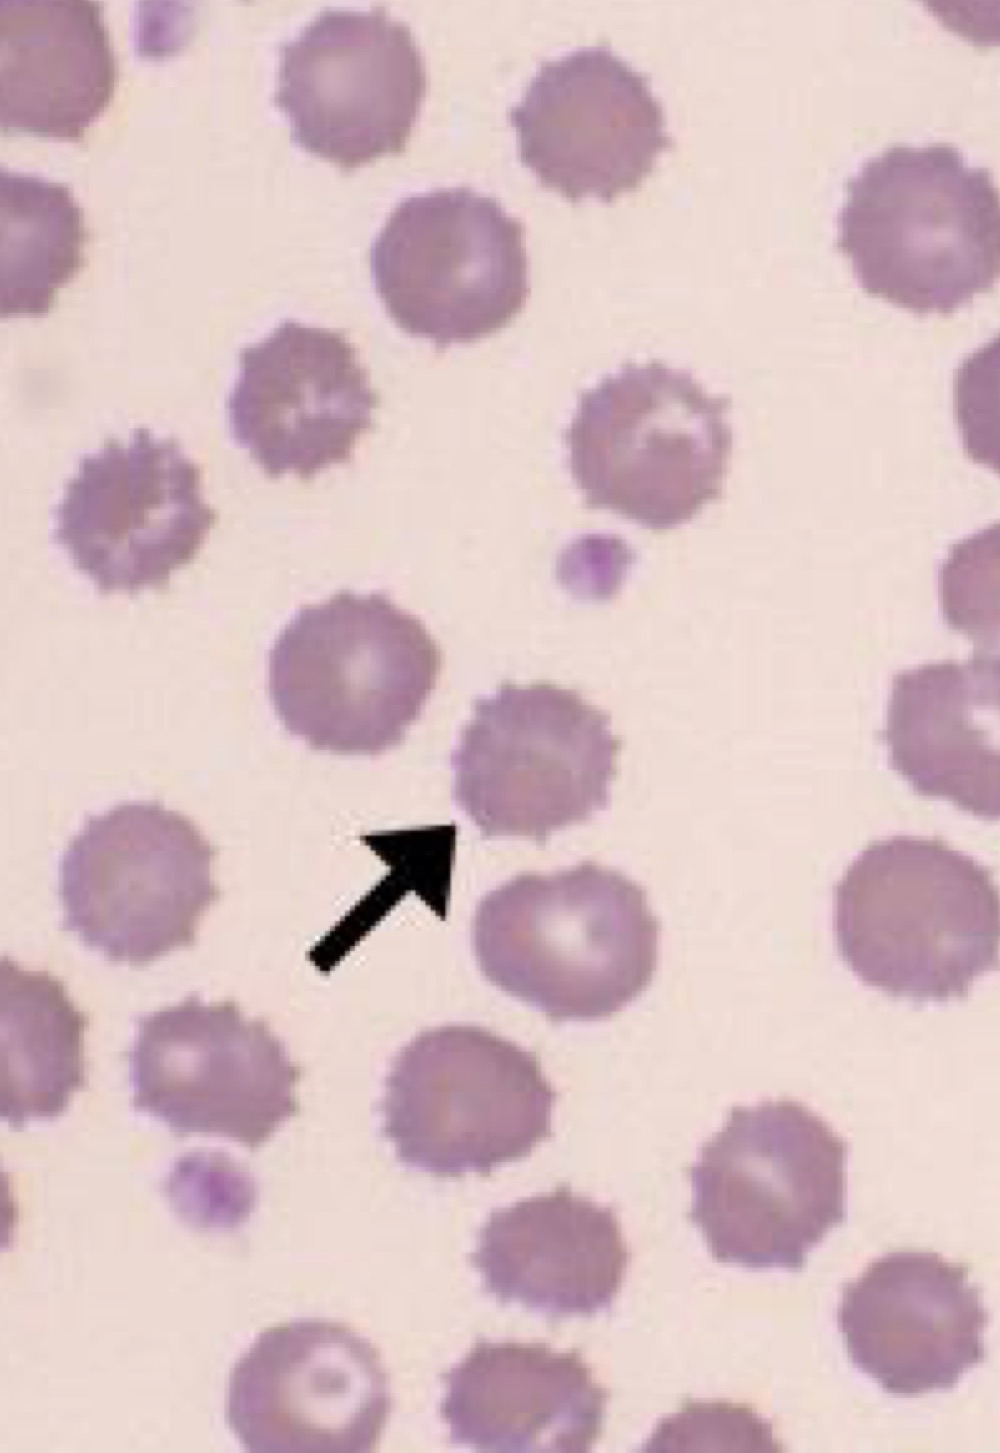
Name this RBC Abnormality.
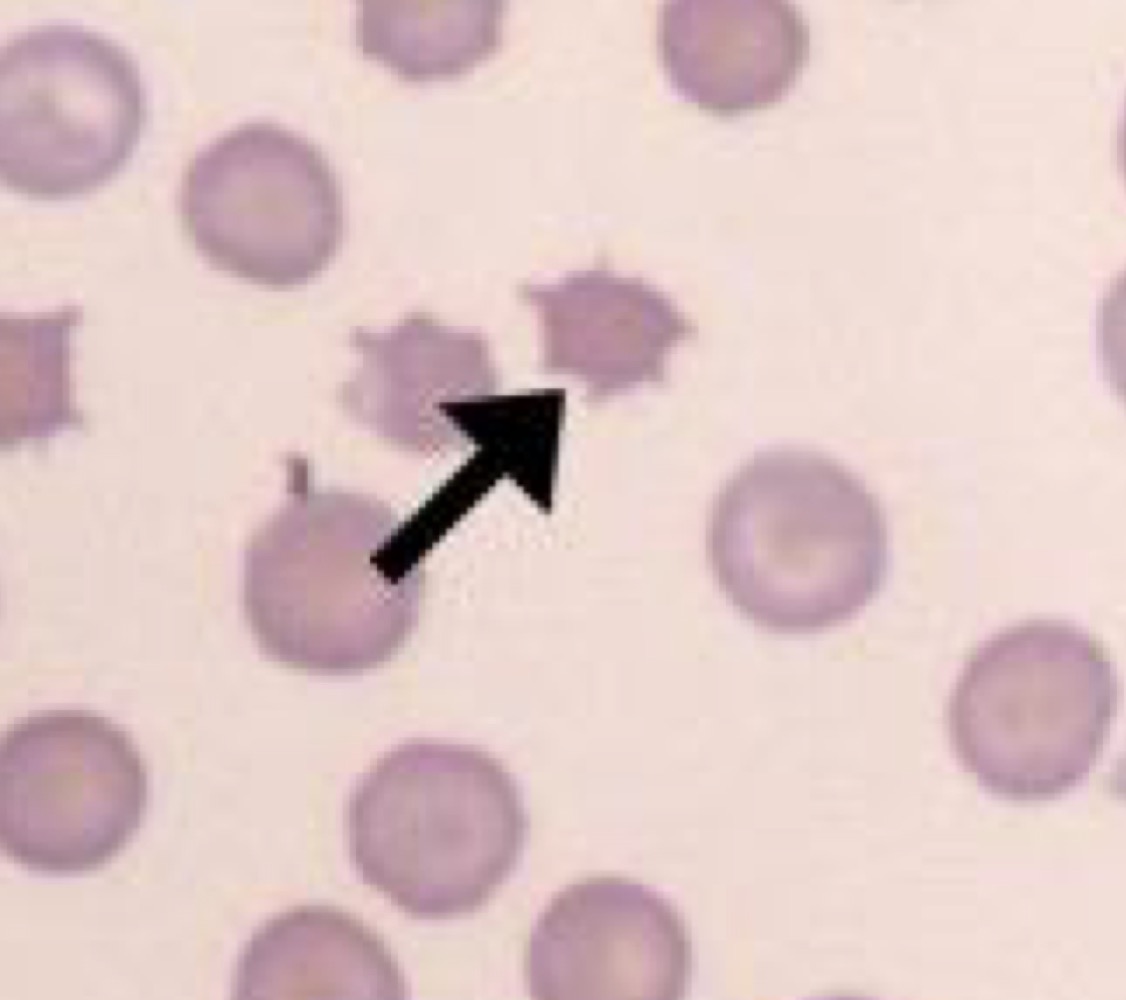
Name this RBC Abnormality.
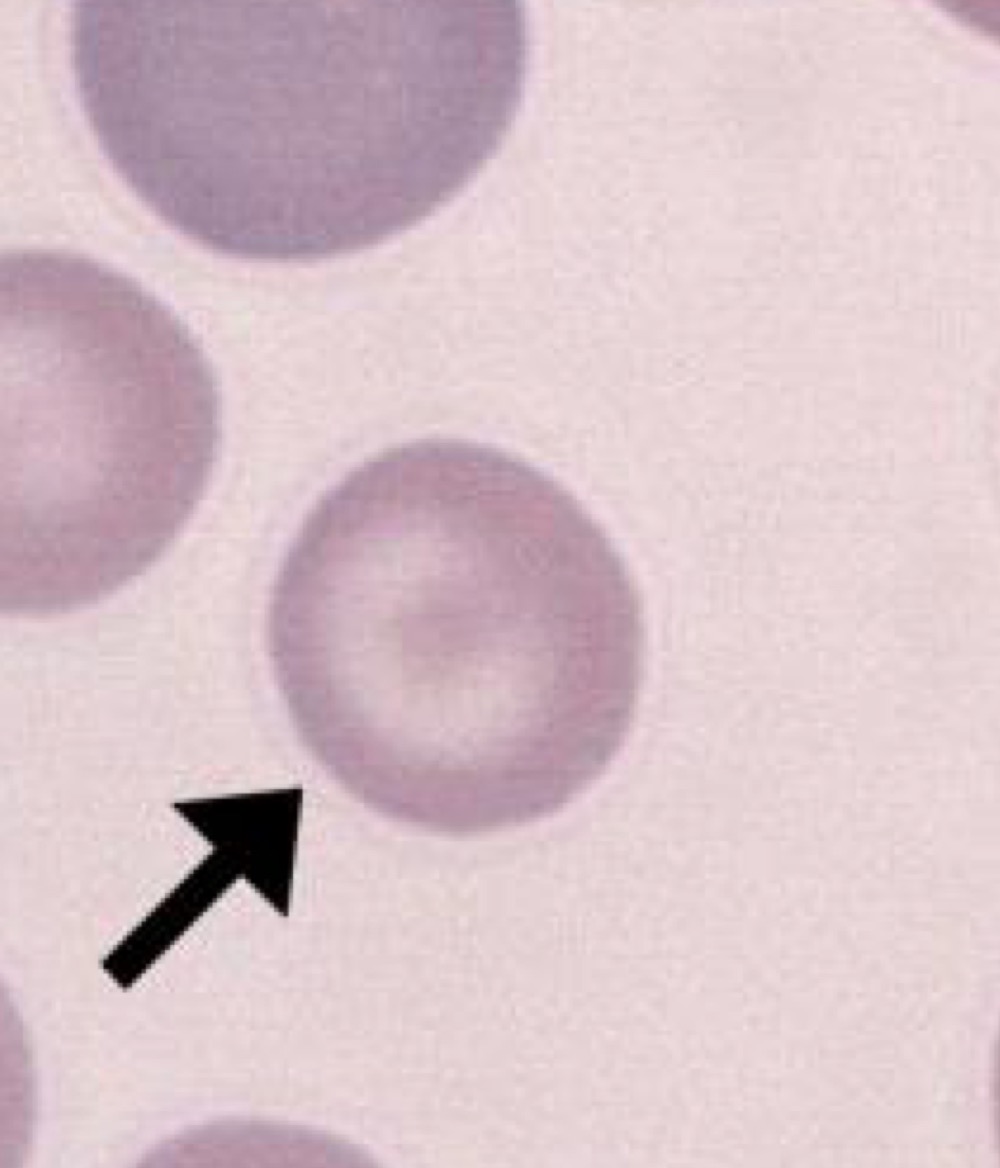
Name this RBC Abnormality.

Identification of All Cells, Parasites, and Other Things found in Urine, Blood, or Cultures
5.0(2)
Studied by 6 peopleCard Sorting
1/40
There's no tags or description
Looks like no tags are added yet.
Last updated 6:42 PM on 5/2/23
Name | Mastery | Learn | Test | Matching | Spaced | Call with Kai |
|---|
No analytics yet
Send a link to your students to track their progress
41 Terms
1
New cards

Identify this Cast.
Hyaline Cast
2
New cards

Identify this Cast.
Granular Cast
3
New cards

Identify this cast.
Epithelial cast
4
New cards

Identify this cast.
Erythrocyte cast
5
New cards

Identify this cast.
Waxy Cast
6
New cards

Identify this cast.
Fatty Cast
7
New cards

Identify this crystal.
Struvite
8
New cards

Identify this crystal.
Calcium Oxalate Dihydrate
9
New cards

Identify this crystal.
Calcium Oxalate Monohydrate
10
New cards

identify this crystal.
Calcium Oxalate Monohydrate from ethylene glycol poisoning
11
New cards

Identify this crystal.
Uric Acid Crystal
12
New cards

Identify this.
Amorphous Crystalline Material
13
New cards

Identify this crystal.
Calcium Carbonate
14
New cards

Identify this crystal.
Ammonium Biurate
15
New cards

Identify this crystal.
Sulfonamide Crystal
16
New cards

Identify this crystal.
Cystine
17
New cards

Identify this crystal.
Melamine Crystal
18
New cards

Identify this cell.
Parabasal Cell
19
New cards

Identify this cell.
Intermediate Epithelial Cell
20
New cards

Identify this cell.
Squamous Epithelial Cells
* Top: Non-cornified
* Bottom: Cornified
* Top: Non-cornified
* Bottom: Cornified
21
New cards
Identify this cell.
Monocyte
22
New cards
Identify this cell.
Neutrophil
23
New cards

Identify this cell.
Lymphocyte
24
New cards

Identify this cell.
Basophil
25
New cards

Identify this cell.
Eosinophil
26
New cards

Identify this parasite.
Microsporum canis
27
New cards

Identify this parasite.
Microsporum gypseum
28
New cards

Identify this parasite.
Trichophyton Mentagrophytes
29
New cards
Name this RBC Abnormality.
Polychromasia
30
New cards

Name this RBC Abnormality.
Hypochromasia
31
New cards
Name this RBC Abnormality.
Poikilocytosis
32
New cards
Name this RBC Abnormality.
Spherocyte
33
New cards
Name this RBC Abnormality.
Helmet Cell (Keratocytes)
34
New cards
Name this RBC Abnormality.
Blister Cell (Keratocyte)
35
New cards
Name this RBC Abnormality.
Schistocytes
36
New cards
Name this RBC Abnormality.
Eccentrocytes
37
New cards
Name this RBC Abnormality.
Echinocytes
38
New cards
Name this RBC Abnormality.
Acanthocyte
39
New cards
Name this RBC Abnormality.
Codocyte (only in dogs)
40
New cards

Name this RBC Abnormality.
Basophillic Stippling
41
New cards

Name this RBC Abnormality.
Heinz Body